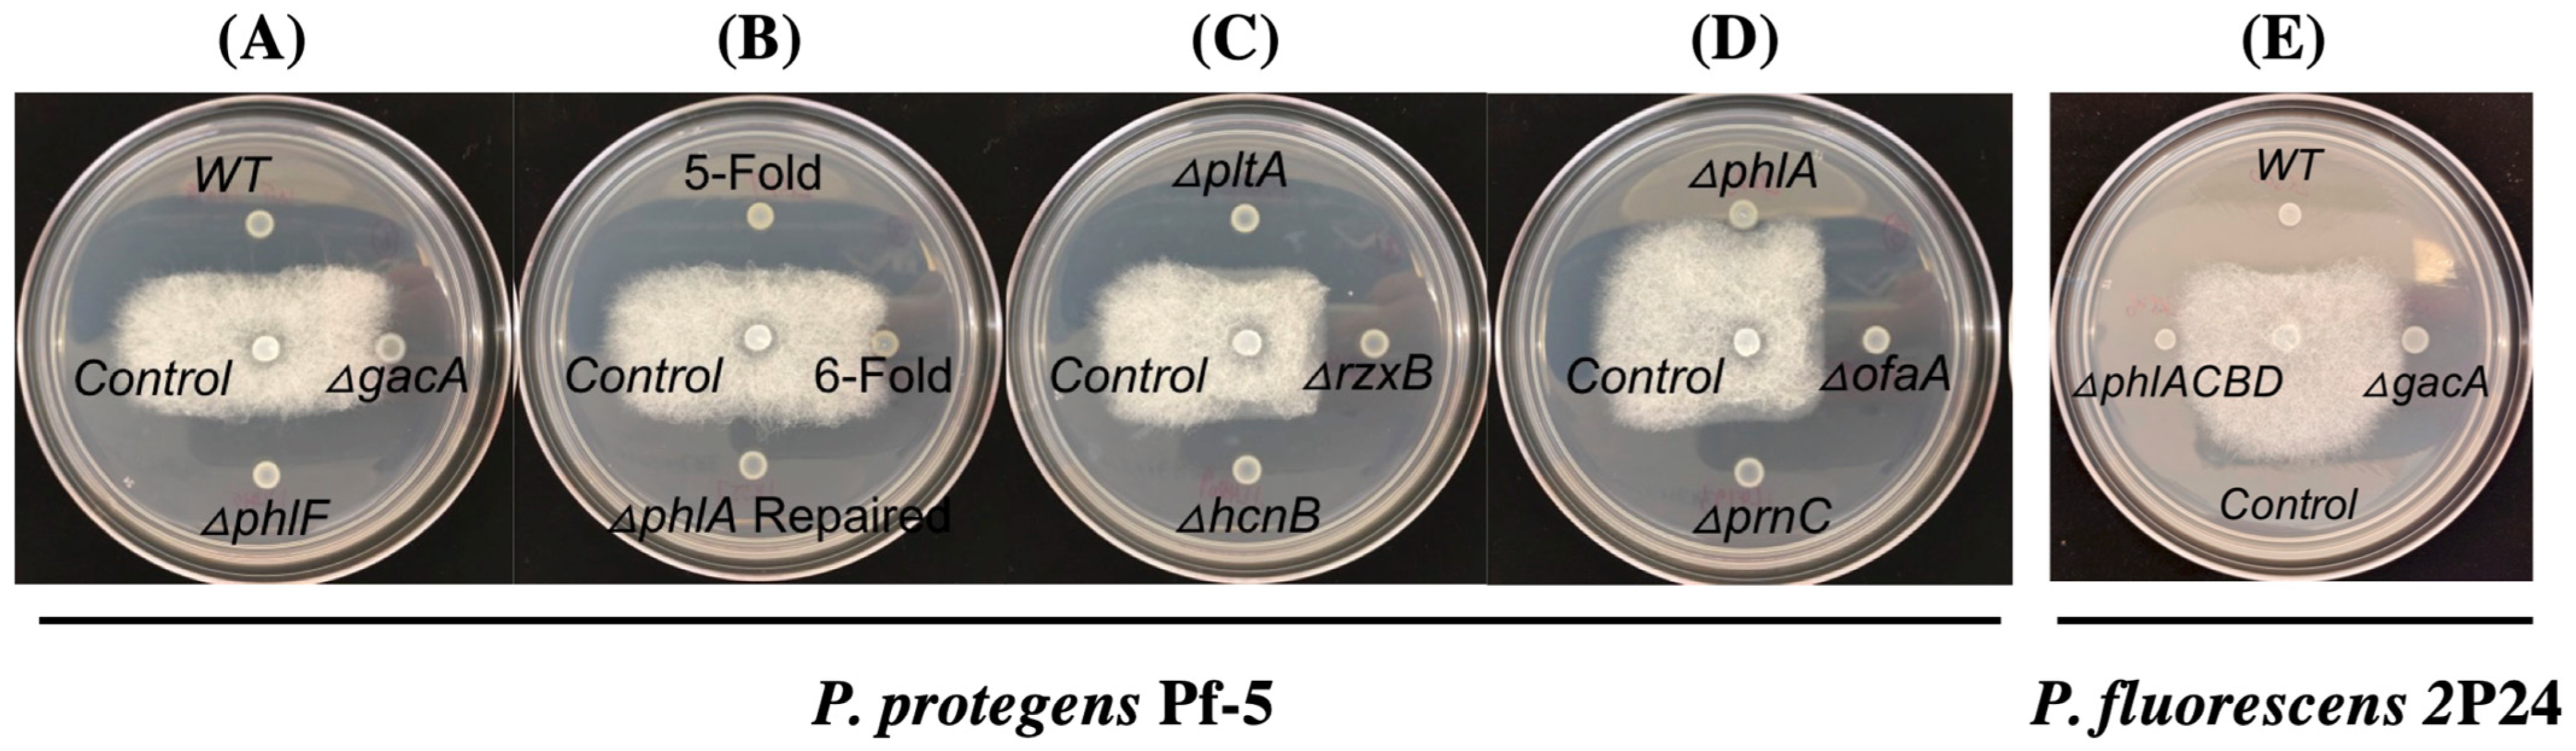
Microorganisms 10 01596 g002

Identification and Characterization of Bacteria-Derived Antibiotics for the Biological Control of Pea Aphanomyces Root Rot
Abstract
1. Introduction
2. Materials and Methods
2.1. Strains and Cultural Conditions
2.2. Isolation and Identification of Pea-Associated Bacterial Antagonists
| Strains, Plasmids, and Primers | Genotypes, Relevant Characteristics, and DNA Sequences # | Reference or Source |
|---|---|---|
| A. euteiches | Oomycete pathogen isolated from pea Aphanomyces root rot disease sample in Montana. | [24] |
| P. protegens strains: | ||
| LK099 | Wild type Pf-5, soil isolate, DAPG+, Ofa+, Prn+, Plt+, HCN+, Rzx+. | [25] |
| JL4975 | ΔgacAPf-5, altered in the many phenotypes regulated by GacA, DAPG−, Ofa−, Prn−, Plt−, HCN−, Rzx−. | [11] |
| LK147 | 6-fold mutant of Pf-5, ΔpltAΔpcnCΔofaAΔrzxBΔhcnBΔphlA, DAPG−, Ofa−, Prn−, Plt−, HCN−, Rzx−. | [26] |
| LK107 | 5-fold mutant of Pf-5, ΔpltAΔpcnCΔofaAΔrzxBΔhcnB, produces DAPG+, Ofa−, Prn−, Plt−, HCN−, Rzx−. | This study |
| LK023 | ΔphlAPf-5, DAPG−. | [27] |
| LK557 | phlA repaired, DAPG+. | This study |
| LK410 | ΔphlFPf-5, overproduces DAPG, DAPG++ | This study |
| JL4776 | ΔofaAPf-5, Ofa− | [28] |
| JL4793 | ΔpcnCPf-5, Prn− | [11] |
| JL4805 | ΔpltAPf-5, Plt− | [11] |
| JL4808 | ΔrzxBPf-5, Rzx− | [11] |
| JL4809 | ΔhcnBPf-5, HCN− | [29] |
| P. fluorescens strains: | ||
| LK500 | Wild type strain 2P24, wheat rhizosphere isolate, wild type, produce DAPG and HCN. | [30] |
| LK501 | ΔgacA2P24, altered in the many phenotypes regulated by GacA, DAPG−, HCN− | [31] |
| LK506 | ΔphlACBD2P24, DAPG−. This mutant also has a deleted phlG gene and lacks PhlG that degrades DAPG to MAPG. | [32] |
| Plasmids | ||
| pEX18Tx | Gene replacement vector with MCS from pUC18, sacB+ Tcr | [33] |
| pEX18Tc-phlA | pEX18Tc containing wild-type phlAPf-5 gene for repair of phlA mutation in the chromosome. | This study |
| pEX18Tc-phlD | pEX18Tc containing wild-type phlDPf-5 gene for repair of phlD mutation in the chromosome. | This study |
| pEX18Tc-ΔphlF | pEX18Tc containing phlFPf-5 with a 546-bp in-frame deletion. | This study |
| pPROBE-NT | pBBR1 containing a promoter-less gfp, Kmr | [34] |
| pphlApromoter-gfp | pPROBE-NT containing the promoter of phlAPf-5 fused with a promoter-less gfp. Kmr | This study |
| pphlAtranslation-gfp | pPROBE-NT containing the promoter and the first seven codons of phlAPf-5 fused with a promoter-less gfp. Kmr | This study |
| Primers | oligonucleotide sequences (5′ to 3′) * | |
| phlA-F3 | ATAGGATCCTTAAGGATTTCGATGGTGG | |
| phlA-R3 | ATAGGTACCTGTTGCGGTTGATGGTGTCGGCG | |
| phlA_HindIII-F | GGACACAAGCTTCCCTATTTGGAGTCTGCTGT | |
| phlA_HindIII-R | CACACCAAGCTTTTCACATTCAGTGCTGGAGC | |
| gfp-phlA-f1 | CTGCAGGTCGACTCTAGAGTCGATGGTGGAAGTGAGAATG | |
| gfp-phlA-r1 | AGTGAAAAGTTCTTCTCCTTTACTCATGACAATACCTATCTTTTTCAC | |
| phlA-gfp-f1 | GTGAAAAAGATAGGTATTGTCATGAGTAAAGGAGAAGAA CTTTTCAC | |
| phlA-gfp-r1 | CATTCTCACTTCCACCATCGACTCTAGAGTCGACCTGCAG | |
| phlF-UpF-Hind3 | TATAAGCTTGAGGTCGGTGTTTTTCC | |
| phlF-UpR-ovlp | TCAACGTTGCGTACCAGGACAAGAGCCGATGGAGCTGCG | |
| phlF-DnF-ovlp | CGCAGCTCCATCGGCTCTTGTCCTGGTACGCAACGTTGA | |
| phlF-DnR-EcoRI | ATAGAATTCAAGTGGTGGTTCATCTGG C | |
| Pf5-phlD-UpF-Hind | CGACACAAGCTTCAGTGCGAAGAATGCAACGA | |
| Pf5-phlD-DnR-Hind | CCTCTCAAGCTTTGGTGACAATGATGCTGGTG | |
| 27f | AGAGTTTGATCCTGGCTCAG | |
| 1492r | CGGTTACCTTGTTACGACTT | |
2.3. Inhibition Assays against A. euteiches
2.4. Construction of Pf-5 Mutant and Derivatives
2.5. Construction of Reporter Strains and GFP Activity Assays
2.6. Biocontrol Assays and Disease Evaluations
2.7. Statistical Analysis
3. Results
3.1. Isolation and Identification of Bacterial Antagonists

3.2. 2,4-DAPG Biosynthesis Pathway Is Required for the Inhibition of A. euteiches by Strains Pf-5 and 2P24
3.3. Purified 2,4-DAPG Suppresses A. euteiches Growth and Alters Its Mycelia Morphology
3.4. Expression of the 2,4-DAPG Biosynthesis Genes Is Induced by Germinating Pea Seeds
3.5. 2,4-DAPG Plays a Role in the Biocontrol of Pea Aphanomyce Root Rot
4. Discussion
Supplementary Materials
Author Contributions
Funding
Acknowledgments
Conflicts of Interest
References
- O’Brien, P.A. Biological control of plant diseases. Australas. Plant Pathol. 2017, 46, 293–304. [Google Scholar] [CrossRef]
- Köhl, J.; Kolnaar, R.; Ravensberg, W.J. Mode of action of microbial biological control agents against plant diseases: Relevance beyond efficacy. Front. Plant Sci. 2019, 10, 845. [Google Scholar] [CrossRef]
- Gaulin, E.; Jacquet, C.; Bottin, A.; Dumas, B. Root rot disease of legumes caused by Aphanomyces euteiches. Mol. Plant Pathol. 2007, 8, 539–548. [Google Scholar] [CrossRef] [PubMed]
- Wu, L.; Chang, K.-F.; Hwang, S.-F.; Conner, R.; Fredua-Agyeman, R.; Feindel, D.; Strelkov, S.E. Evaluation of host resistance and fungicide application as tools for the management of root rot of field pea caused by Aphanomyces euteiches. Crop J. 2019, 7, 38–48. [Google Scholar] [CrossRef]
- Quillévéré-Hamard, A.; Le Roy, G.; Lesné, A.; Le May, C.; Pilet-Nayel, M.-L. Aggressiveness of Diverse French Aphanomyces euteiches Isolates on Pea Near Isogenic Lines Differing in Resistance Quantitative Trait Loci. Phytopathology® 2021, 111, 695–702. [Google Scholar] [CrossRef]
- Heungens, K.; Parke, J.L. Postinfection biological control of oomycete pathogens of pea by Burkholderia cepacia AMMDR1. Phytopathology 2001, 91, 383–391. [Google Scholar] [CrossRef] [PubMed][Green Version]
- Wakelin, S.A.; Walter, M.; Jaspers, M.; Stewart, A. Biological control of Aphanomyces euteiches root-rot of pea with spore-forming bacteria. Australas. Plant Pathol. 2002, 31, 401–407. [Google Scholar] [CrossRef]
- Godebo, A.T.; Germida, J.J.; Walley, F.L. Isolation, identification, and assessment of soil bacteria as biocontrol agents of pea root rot caused by Aphanomyces euteiches. Can. J. Soil Sci. 2020, 100, 206–216. [Google Scholar] [CrossRef]
- Beneduzi, A.; Ambrosini, A.; Passaglia, L.M. Plant growth-promoting rhizobacteria (PGPR): Their potential as antagonists and biocontrol agents. Genet. Mol. Biol. 2012, 35, 1044–1051. [Google Scholar] [CrossRef]
- Parke, J.; Rand, R.; Joy, A.; King, E. Biological control of Pythium damping-off and Aphanomyces root rot of peas by application of Pseudomonas cepacia or P. fluorescens to seed. Plant Dis. 1991, 75, 987–992. [Google Scholar] [CrossRef]
- Henkels, M.D.; Kidarsa, T.A.; Shaffer, B.T.; Goebel, N.C.; Burlinson, P.; Mavrodi, D.V.; Bentley, M.A.; Rangel, L.I.; Davis, E.W.; Thomashow, L.S.; et al. Pseudomonas protegens Pf-5 causes discoloration and pitting of mushroom caps due to the production of antifungal metabolites. Mol. Plant-Microbe Interact. 2014, 27, 733–746. [Google Scholar] [CrossRef]
- Philmus, B.; Shaffer, B.T.; Kidarsa, T.A.; Yan, Q.; Raaijmakers, J.M.; Begley, T.P.; Loper, J.E. Investigations into the biosynthesis, regulation, and self-resistance of toxoflavin in Pseudomonas protegens Pf-5. ChemBioChem 2015, 16, 1782–1790. [Google Scholar] [CrossRef]
- Yan, Q.; Philmus, B.; Chang, J.H.; Loper, J.E. Novel mechanism of metabolic co-regulation coordinates the biosynthesis of secondary metabolites in Pseudomonas protegens. eLife 2017, 6, e22835. [Google Scholar] [CrossRef] [PubMed]
- Yan, Q.; Lopes, L.D.; Shaffer, B.T.; Kidarsa, T.A.; Vining, O.; Philmus, B.; Song, C.; Stockwell, V.O.; Raaijmakers, J.M.; McPhail, K.L.; et al. Secondary Metabolism and Interspecific Competition Affect Accumulation of Spontaneous Mutants in the GacS-GacA Regulatory System in Pseudomonas protegens. mBio 2018, 9, e01845-17. [Google Scholar] [CrossRef]
- Zhang, W.; Zhao, Z.; Zhang, B.; Wu, X.-G.; Ren, Z.-G.; Zhang, L.-Q. Posttranscriptional regulation of 2, 4-diacetylphloroglucinol production by GidA and TrmE in Pseudomonas fluorescens 2P24. Appl. Environ. Microbiol. 2014, 80, 3972–3981. [Google Scholar] [CrossRef] [PubMed]
- Liang, F.; Zhang, B.; Yang, Q.; Zhang, Y.; Zheng, D.; Zhang, L.; Yan, Q.; Wu, X. Cyclic-di-GMP regulates the quorum-sensing system and the biocontrol activity of Pseudomonas fluorescens 2P24 through RsmA and RsmE proteins. Appl. Environ. Microbiol. 2020, 86, e02016-20. [Google Scholar] [CrossRef] [PubMed]
- King, E.O.; Ward, M.K.; Raney, D.E. Two simple media for the demonstration of pyocyanin and fluorescin. J. Lab. Clin. Med. 1954, 44, 301–307. [Google Scholar]
- Beckerman, J.; Stone, J.; Ruhl, G.; Creswell, T. First report of Pythium ultimum crown and root rot of industrial hemp in the United States. Plant Dis. 2018, 102, 2045. [Google Scholar] [CrossRef]
- Linaldeddu, B.T.; Bregant, C.; Ruzzon, B.; Montecchio, L. Coniella granati and Phytophthora palmivora the main pathogens involved in pomegranate dieback and mortality in north-eastern Italy. Ital. J. Mycol. 2020, 49, 92–100. [Google Scholar]
- Eden, P.A.; Schmidt, T.M.; Blakemore, R.P.; Pace, N.R. Phylogenetic analysis of Aquaspirillum magnetotacticum using polymerase chain reaction-amplified 16S rRNA-specific DNA. Int. J. Syst. Evol. Microbiol. 1991, 41, 324–325. [Google Scholar] [CrossRef]
- Katoh, K.; Misawa, K.; Kuma, K.; Miyata, T. MAFFT: A Novel Method for Rapid Multiple Sequence Alignment Based on Fast Fourier Transform. Nucleic Acids Res. 2002, 30, 3059–3066. [Google Scholar] [CrossRef]
- Miller, M.A.; Pfeiffer, W.; Schwartz, T. Creating the CIPRES Science Gateway for Inference of Large Phylogenetic Trees. In Proceedings of the 2010 Gateway Computing Environments Workshop (GCE), New Orleans, LA, USA, 14 November 2010; pp. 1–8. [Google Scholar]
- Minh, B.Q.; Schmidt, H.A.; Chernomor, O.; Schrempf, D.; Woodhams, M.D.; von Haeseler, A.; Lanfear, R. IQ-TREE, 2, New Models and Efficient Methods for Phylogenetic Inference in the Genomic Era. Mol. Biol. Evol. 2020, 37, 1530–1534. [Google Scholar] [CrossRef]
- Parikh, L.; Agindotan, B.O.; Burrows, M.E. Antifungal activity of plant-derived essential oils on pathogens of pulse crops. Plant Dis. 2021, 105, 1692–1701. [Google Scholar] [CrossRef]
- Howell, C.R.; Stipanovic, R.D. Control of Rhizoctonia solani in cotton seedlings with Pseudomonas fluorescens and with an antibiotic produced by the bacterium. Phytopathology 1979, 69, 480–482. [Google Scholar] [CrossRef]
- Loper, J.E.; Henkels, M.D.; Rangel, L.I.; Olcott, M.H.; Walker, F.L.; Bond, K.L.; Kidarsa, T.A.; Hesse, C.N.; Sneh, B.; Stockwell, V.O.; et al. Rhizoxin analogs, orfamide A and chitinase production contribute to the toxicity of Pseudomonas protegens strain Pf-5 to Drosophila melanogaster. Environ. Microbiol. 2016, 18, 3509–3521. [Google Scholar] [CrossRef]
- Kidarsa, T.A.; Goebel, N.C.; Zabriskie, T.M.; Loper, J.E. Phloroglucinol mediates cross-talk between the pyoluteorin and 2,4-diacetylphloroglucinol biosynthetic pathways in Pseudomonas fluorescens Pf-5. Mol. Microbiol. 2011, 81, 395–414. [Google Scholar] [CrossRef]
- Gross, H.; Stockwell, V.O.; Henkels, M.D.; Nowak-Thompson, B.; Loper, J.E.; Gerwick, W.H. The genomisotopic approach: A systematic method to isolate products of orphan biosynthetic gene clusters. Chem. Biol. 2007, 14, 53–63. [Google Scholar] [CrossRef]
- Loper, J.E.; Hassan, K.A.; Mavrodi, D.V.; Davis II, E.W.; Lim, C.K.; Shaffer, B.T.; Elbourne, L.D.; Stockwell, V.O.; Hartney, S.L.; Breakwell, K.; et al. Comparative genomics of plant-associated Pseudomonas spp.: Insights into diversity and inheritance of traits involved in multitrophic interactions. PLoS Genet. 2012, 8, e1002784. [Google Scholar] [CrossRef]
- Wei, H.-L.; Zhang, L.-Q. Quorum-sensing system influences root colonization and biological control ability in Pseudomonas fluorescens 2P24. Antonie Leeuwenhoek 2006, 89, 267–280. [Google Scholar] [CrossRef]
- Yan, Q.; Wu, X.-G.; Wei, H.-L.; Wang, H.-M.; Zhang, L.-Q. Differential control of the PcoI/PcoR quorum-sensing system in Pseudomonas fluorescens 2P24 by sigma factor RpoS and the GacS/GacA two-component regulatory system. Microbiol. Res. 2009, 164, 18–26. [Google Scholar] [CrossRef]
- Yan, X.; Yang, R.; Zhao, R.-X.; Han, J.-T.; Jia, W.-J.; Li, D.-Y.; Wang, Y.; Zhang, N.; Wu, Y.; Zhang, L.-Q.; et al. Transcriptional Regulator PhlH Modulates 2, 4-Diacetylphloroglucinol Biosynthesis in Response to the Biosynthetic Intermediate and End Product. Appl. Environ. Microbiol. 2017, 83, e01419-17. [Google Scholar] [CrossRef]
- Hoang, T.T.; Karkhoff-Schweizer, R.R.; Kutchma, A.J.; Schweizer, H.P. A broad-host-range Flp-FRT recombination system for site-specific excision of chromosomally-located DNA sequences: Application for isolation of unmarked Pseudomonas aeruginosa mutants. Gene 1998, 212, 77–86. [Google Scholar] [CrossRef]
- Miller, W.G.; Leveau, J.H.; Lindow, S.E. Improved gfp and inaZ broad-host-range promoter-probe vectors. Mol. Plant-Microbe Interact. 2000, 13, 1243–1250. [Google Scholar] [CrossRef]
- Yan, Q.; Liu, M.; Kidarsa, T.; Johnson, C.P.; Loper, J.E. Two Pathway-Specific Transcriptional Regulators, PltR and PltZ, Coordinate Autoinduction of Pyoluteorin in Pseudomonas protegens Pf-5. Microorganisms 2021, 9, 1489. [Google Scholar] [CrossRef]
- Quecine, M.C.; Kidarsa, T.A.; Goebel, N.C.; Shaffer, B.T.; Henkels, M.D.; Zabriskie, T.M.; Loper, J.E. An Interspecies signaling system mediated by fusaric acid has parallel effects on antifungal metabolite production by Pseudomonas protegens Pf-5 and antibiosis of Fusarium spp. Appl. Environ. Microbiol. 2016, 82, 1372–1382. [Google Scholar] [CrossRef]
- Yan, Q.; Philmus, B.; Hesse, C.; Kohen, M.; Chang, J.H.; Loper, J. The rare codon AGA is involved in regulation of pyoluteorin biosynthesis in Pseudomonas protegens Pf-5. Front. Microbiol. 2016, 7, 497. [Google Scholar] [CrossRef]
- Windels, C.E. Aphanomyces Root Rot on Sugar Beet. Plant Health Prog. 2000, 1, 8. [Google Scholar] [CrossRef]
- Papavizas, G.C.; Ayers, W.A. Aphanomyces Species and Their Root Diseases in Pea and Sugar Beet: A Review; Agricultural Research Service, U.S. Department of Agriculture: Washington, DC, USA, 1974.
- Kidarsa, T.A.; Shaffer, B.T.; Goebel, N.C.; Roberts, D.P.; Buyer, J.S.; Johnson, A.; Kobayashi, D.Y.; Zabriskie, T.M.; Paulsen, I.; Loper, J.E. Genes expressed by the biological control bacterium Pseudomonas protegens Pf-5 on seed surfaces under the control of the global regulators GacA and RpoS. Environ. Microbiol. 2013, 15, 716–735. [Google Scholar] [CrossRef]
- Gleeson, O.; O’Gara, F.; Morrissey, J. The Pseudomonas fluorescens secondary metabolite 2,4 diacetylphloroglucinol impairs mitochondrial function in Saccharomyces cerevisiae. Antonie Leeuwenhoek 2010, 97, 261–273. [Google Scholar] [CrossRef]
- Biessy, A.; Filion, M. Phloroglucinol Derivatives in Plant-Beneficial Pseudomonas spp.: Biosynthesis, Regulation, and Functions. Metabolites 2021, 11, 182. [Google Scholar] [CrossRef]
- Ali, M.A.; Luo, J.; Ahmed, T.; Zhang, J.; Xie, T.; Dai, D.; Jiang, J.; Zhu, J.; Hassan, S.; Alorabi, J.A.; et al. Pseudomonas bijieensis Strain XL17 within the P. corrugata Subgroup Producing 2,4-Diacetylphloroglucinol and Lipopeptides Controls Bacterial Canker and Gray Mold Pathogens of Kiwifruit. Microorganisms 2022, 10, 425. [Google Scholar] [CrossRef]
- Delany, I.; Sheehan, M.M.; Fenton, A.; Bardin, S.; Aarons, S.; O’Gara, F. Regulation of production of the antifungal metabolite 2,4-diacetylphloroglucinol in Pseudomonas fluorescens F113: Genetic analysis of phlF as a transcriptional repressor. Microbiology 2000, 146, 537–543. [Google Scholar] [CrossRef]
- Islam, M.T.; Von Tiedemann, A. 2,4-Diacetylphloroglucinol suppresses zoosporogenesis and impairs motility of Peronosporomycete zoospores. World J. Microbiol. Biotechnol. 2011, 27, 2071–2079. [Google Scholar] [CrossRef]
- Howell, C.R.; Stipanovic, R.D. Suppression of Pythium ultimum-induced damping-off of cotton seedlings by Pseudomonas fluorescens and its antibiotic, pyoluteorin. Phytopathology 1980, 70, 712–715. [Google Scholar] [CrossRef]
- Chernin, L.; Brandis, A.; Ismailov, Z.; Chet, I. Pyrrolnitrin production by an Enterobacter agglomerans strain with a broad spectrum of antagonistic activity towards fungal and bacterial phytopathogens. Curr. Microbiol. 1996, 32, 208–212. [Google Scholar] [CrossRef]
- Loper, J.E.; Kobayashi, D.Y.; Paulsen, I.T. The genomic sequence of Pseudomonas fluorescens Pf-5: Insights into biological control. Phytopathology 2007, 97, 233–238. [Google Scholar] [CrossRef]
- Loper, J.E.; Henkels, M.D.; Shaffer, B.T.; Valeriote, F.A.; Gross, H. Isolation and identification of rhizoxin analogs from Pseudomonas fluorescens Pf-5 by using a genomic mining strategy. Appl. Environ. Microbiol. 2008, 74, 3085–3093. [Google Scholar] [CrossRef]
- Anand, A.; Chinchilla, D.; Tan, C.; Mène-Saffrané, L.; L’Haridon, F.; Weisskopf, L. Contribution of hydrogen cyanide to the antagonistic activity of Pseudomonas strains against Phytophthora infestans. Microorganisms 2020, 8, 1144. [Google Scholar] [CrossRef]
- Kraus, J.; Loper, J.E. Characterization of a genomic region required for production of the antibiotic pyoluteorin by the biological control agent Pseudomonas fluorescens Pf-5. Appl. Environ. Microbiol. 1995, 61, 849–854. [Google Scholar] [CrossRef]
- Zhao, Y.; Qian, G.; Chen, Y.; Du, L.; Liu, F. Transcriptional and antagonistic responses of biocontrol strain Lysobacter enzymogenes OH11 to the plant pathogenic oomycete Pythium aphanidermatum. Front. Microbiol. 2017, 8, 1025. [Google Scholar] [CrossRef]
- Christiansen, L.; Alanin, K.S.; Phippen, C.B.; Olsson, S.; Stougaard, P.; Hennessy, R.C. Fungal-associated molecules induce key genes involved in the biosynthesis of the antifungal secondary metabolites nunamycin and nunapeptin in the biocontrol strain Pseudomonas fluorescens In5. Appl. Environ. Microbiol. 2020, 86, e01284-20. [Google Scholar] [CrossRef] [PubMed]
- Yu, X.-Q.; Yan, X.; Zhang, M.-Y.; Zhang, L.-Q.; He, Y.-X. Flavonoids repress production of antifungal 2,4-DAPG but potentially facilitate root colonization of the rhizobacterium Pseudomonas fluorescens. Environ. Microbiol. 2020, 22, 5073–5089. [Google Scholar] [CrossRef] [PubMed]
- Jousset, A.; Rochat, L.; Lanoue, A.; Bonkowski, M.; Keel, C.; Scheu, S. Plants Respond to Pathogen Infection by Enhancing the Antifungal Gene Expression of Root-Associated Bacteria. Mol. Plant-Microbe Interact. 2011, 24, 352–358. [Google Scholar] [CrossRef]
- Höfte, M. The Use of Pseudomonas spp. as Bacterial Biocontrol Agents to Control Plant Disease; Burleigh Dodds Science Publishing Limited: Cambridge, UK, 2021. [Google Scholar]
- Raaijmakers, J.M.; De Bruijn, I.; Nybroe, O.; Ongena, M. Natural functions of lipopeptides from Bacillus and Pseudomonas: More than surfactants and antibiotics. FEMS Microbiol. Rev. 2010, 34, 1037–1062. [Google Scholar] [CrossRef]
- Jeong, H.; Choi, S.-K.; Ryu, C.-M.; Park, S.-H. Chronicle of a soil bacterium: Paenibacillus polymyxa E681 as a tiny guardian of plant and human health. Front. Microbiol. 2019, 10, 467. [Google Scholar] [CrossRef]
- Tindall, B.J.; Rosselló-Móra, R.; Busse, H.-J.; Ludwig, W.; Kämpfer, P. Notes on the characterization of prokaryote strains for taxonomic purposes. Int. J. Syst. Evol. Microbiol. 2010, 60, 249–266. [Google Scholar] [CrossRef]
- Nikolaidis, M.; Mossialos, D.; Oliver, S.G.; Amoutzias, G.D. Comparative analysis of the core proteomes among the Pseudomonas major evolutionary groups reveals species-specific adaptations for Pseudomonas aeruginosa and Pseudomonas chlororaphis. Diversity 2020, 12, 289. [Google Scholar] [CrossRef]

Publisher’s Note: MDPI stays neutral with regard to jurisdictional claims in published maps and institutional affiliations. |
© 2022 by the authors. Licensee MDPI, Basel, Switzerland. This article is an open access article distributed under the terms and conditions of the Creative Commons Attribution (CC BY) license (https://creativecommons.org/licenses/by/4.0/).
Share and Cite
Lai, X.; Niroula, D.; Burrows, M.; Wu, X.; Yan, Q. Identification and Characterization of Bacteria-Derived Antibiotics for the Biological Control of Pea Aphanomyces Root Rot. Microorganisms 2022, 10, 1596. https://doi.org/10.3390/microorganisms10081596
Lai X, Niroula D, Burrows M, Wu X, Yan Q. Identification and Characterization of Bacteria-Derived Antibiotics for the Biological Control of Pea Aphanomyces Root Rot. Microorganisms. 2022; 10(8):1596. https://doi.org/10.3390/microorganisms10081596
Chicago/Turabian StyleLai, Xiao, Dhirendra Niroula, Mary Burrows, Xiaogang Wu, and Qing Yan. 2022. "Identification and Characterization of Bacteria-Derived Antibiotics for the Biological Control of Pea Aphanomyces Root Rot" Microorganisms 10, no. 8: 1596. https://doi.org/10.3390/microorganisms10081596
APA StyleLai, X., Niroula, D., Burrows, M., Wu, X., & Yan, Q. (2022). Identification and Characterization of Bacteria-Derived Antibiotics for the Biological Control of Pea Aphanomyces Root Rot. Microorganisms, 10(8), 1596. https://doi.org/10.3390/microorganisms10081596

